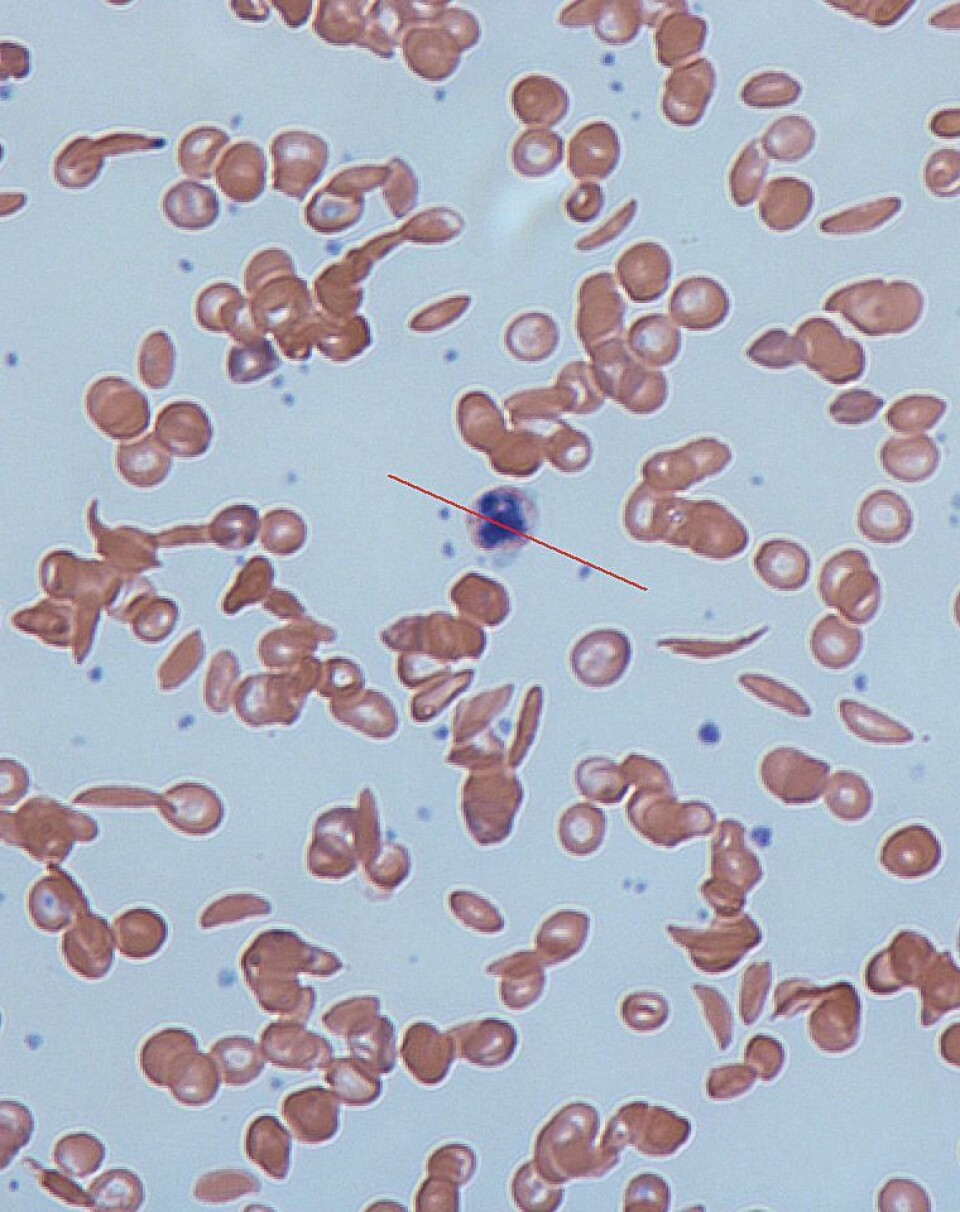

Pest eller kolera? I hvert fall ikke begge deler
Om du får kreft, er det mindre risiko for at du får Alzheimers, og omvendt. Slik er en hel haug med sykdommer koblet sammen.
Denne artikkelen er over ti år gammel og kan inneholde utdatert informasjon.

En ny studie antyder at i noen tilfeller av det klassiske dilemmaet ”Pest eller kolera?”, vil du i det minste ikke bli salet med mer enn én av delene.
Da forskerne sjekket sykdomsrisikoen for over 200 000 eldre norditalienere, fant de nemlig ut at en Alzheimersdiagnose betydde en lavere risiko for kreft.
Det samme gjaldt den andre veien: Kreft beskyttet mot Alzheimers.
Tidligere forskning har gruppert andre sykdommer i par. Kukopper beskytter mot kopper, og cystisk fibrose ser ut til å gjøre folk ganske immune mot tuberkulose.
Forskerne har ingen generell forklaring på slike tospann, men koblingene kan likevel avsløre mye – både om sykdommene selv, og ikke minst om hvordan vi skal slå dem.
Celleliv-kobling mellom kreft og Alzheimers
Av 204 500 deltagere i kreft-og-Alzheimers-studien, fikk 21 500 kreft og 2800 Alzheimers i løpet av de seks årene forskerne fulgte dem.
Det var bare 161 deltagere som fikk begge sykdommene.
Da Massimo Musicco og kollegene i Italia regnet på tallene, fant de at en kreftdiagnose senket en deltagers risiko for å få Alzheimers med 50 prosent. Alzheimers sykdom senket risikoen for kreft med 35 prosent.
Kreft og Alzheimers er beslektede, men på en måte motsatte sykdommer:
Mens kreft handler om ukontrollert cellevekst, er Alzheimers et ord for unormalt stor celledød i hjernen. Dermed er det heller ikke så unaturlig at de to kan henge sammen. Forskerne spekulerer i om det er visse gener som styrer de beslektede prosessene, slik at det ene utelukker det andre.
Enkeltgen gir fordel, men dobbel dose gjør deg syk
– Det er flere eksempler på slike sykdomskoblinger, mer eller mindre spekulative, sier Anne Spurkland, professor i anatomi og spesialist i immunologi ved Universitetet i Oslo.
Kukopper er det berømte eksempelet: Da Edward Jenner oppdaget at den sykdommer beskyttet mot vanlige kopper, var vaksinen ikke langt unna.
Et mer moderne tospann er en god illustrasjon på hvordan slike sykdomskoblinger kan forklares.
Sigdcelleanemi er en blodsykdom som gjør at de røde blodlegemene i kroppen forandrer litt form. Det kan gjøre at de blir stive og brytes ned raskere, så pasienten blir blodfattig. I noen situasjoner klumper blodlegemene seg og lager blodpropp.
Sykdommen rammer nesten bare afrikanere. Dermed er den lite utbredt i Norge, mens det er mer av den både på det afrikanske kontinentet, og blant afroamerikanere i USA.
– Sigdcelleanemi skyldes en feil på genet for hemoglobin, og om du får den fra både mor og far, risikerer du å bli syk, forteller Spurkland.
– Men genet er veldig utbredt i Afrika fordi det i enkel dose beskytter mot malaria. De som har et enkelt gen har hatt større sjanse for å overleve som barn, derfor er det vanlig i Afrika. Noen mennesker har uflaks og får genet i dobbel dose, men gevinsten fra enkel dose er likevel så stor at feilen har overlevd.
Slimete sykdom beskytter mot dehydrering
Richard Stiehm, en professor ved University of California Los Angeles, skrev i 2006 en artikkel om ”sykdom versus sykdom”, der han samlet opp tilfeller av sykdommer som ser ut til å beskytte mot hverandre.

Et eksempel han skriver om er fra hans egen legehverdag. En travel dag da han var nyutdannet fikk Stiehm inn en pasient med cystisk fibrose (CF). Det er en kronisk og medfødt sykdom som gjør at en del slim, for eksempel i luftveien og i bukspyttkjertelen, blir seigt.
Sykehuset var fullt, og Stiehm lurte på hvor han skulle gjøre av pasienten. Rådet fra overlegen den gangen var å legge vedkommende inn på rommet med de blodhostende, tuberkuløse pasientene:
”CF-pasienter får aldri tuberkulose”, var beskjeden.
– Sammenhengen kan være at det mer seigere slim gjør at tuberkulosen ikke så lett sprer seg, sier Spurkland.
CF er en recessiv sykdom, på samme måte som sigdcelleanemi: Du må få genet fra begge foreldrene dine for å bli syk. Bare én variant av cystisk fibrose-genet kan være en velsignelse, spekulerer Spurkland:
– Det kan være at de som bare bærer genet, men ikke har CF, har en fordel for eksempel i forbindelse med infeksjoner som gjør at du mister mye væske, som kolera. Genet kan kanskje forhindre at du mister så mye vann, og da overlever du lettere, sier Spurkland.
En alternativ kreftteori
Koblingene mellom cystisk fibrose og tuberkulose, og mellom malaria og sigdcelleanemi, er ganske velkjente. Andre koblinger er mer spekulative – men desto mer spennende:
Det handler igjen om kreft, men denne gangen er et hyperaktivt immunforsvar som er koblingen.
Vi er vant til å tenke på kreft som en svikt i immunforsvaret: Det oppdager ikke fremmede celler i kroppen, som dermed får lov til å spre seg fritt. Men hva om immunforsvaret egentlig er ganske effektivt i å stoppe kreftceller?

Dersom den tar ei kreftcelle før den begynner å formere seg, vil vi jo aldri merke noe til kreften.
Dermed er det kanskje en kobling til såkalte autoimmune sykdommer, forklarer Spurkland: Det er sykdommer der immunforsvaret er hyperaktivt, og går til angrep på kroppens eget vev. Multippel sklerose og leddgikt er to eksempler på slike. Kan et overaktivt immunsystem er en bedre kreftjeger?
– Om du forventer mer kreft med svakt immunforsvar, så kan det hende at de med autoimmune sykdommer kanskje har litt mindre kreft, sier Spurkland.
– Det er forskere som har forsøkt å se den koblingen i registre – dukker de med autoimmune sykdommer sjeldnere opp i kreftregistre? Det er ikke sterke holdepunkter, men det finnes resultater som tyder på en slik kobling.
Kan peke ut veien til behandling
Det er altså ingen generell felles forklaring på hvorfor noen sykdommer beskytter mot andre. Man må se på det enkelte tospannet av sykdommer og hva som styrer dem for å forklare hvorfor noen kjipe tilstander i det minste har noen heldige bivirkninger.
Når det gjelder den originale kreft-og-Alzheimers-studien, er Spurkland avventende. Hun mener det trengs andre studier som viser samme kobling før man kan si noe som helst sikkert om noen kobling.
Dersom en slik finnes, vil den imidlertid kunne være en gullgruve for forskerne. Det blir nemlig ofte lettere å se hva som styrer en sykdom, dersom den er forbundet med en annen sykdom.
Det kan gi en indikasjon om nye behandlingsmåter.
Massimo Musicco og kollegene er nysgjerrige på genet P53. Det undertrykker vanligvis svulstvekst, og har vist seg å være inaktivt hos halvparten av kreftpasientene forskerne har undersøkt.
Dessuten mener en del forskere å ha sett en overaktivering av P53 blant alzheimerspasienter – som kan gjøre at det dør flere celler enn det normalt sett burde.
Det kan bety at P53 er en nøkkel til begge sykdommer, og at medisiner eller behandling rettet direkte mot det kan være en måte å angripe dem begge. Det vil i så fall være et episk tilfelle av to fluer i en smekk, for begge sykdommer er notorisk vanskelige å stoppe.

Kilder:
M. Musicco m.fl. (2013) Inverse occurrence of cancer and Alzheimer disease: A population-based incidence study. Neurology, publisert på nett 10. juli 2013 (les sammendrag)
E. R. Stiehm (2006) Disease Versus Disease: How One Disease May Ameliorate Another. Pediatrics, vol 117, side 184-191
E.M Poolman og A.P. Galvani (2007) Evaluating candidate agents of selective pressure for cystic fibrosis. Royal Society: Interface, vol. 4, nr. 12, side 91-98 (les sammendrag)